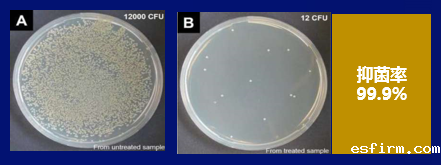

2021年12月3日
10月21日,“百品发布·百家对接”——“培育和推广2021年度十大类纺织创新产品”颁奖典礼暨百家品牌与盛泽面料企业精准对接会在江苏省苏州市吴江区盛泽镇举办。
该项活动得到了CCTV-1、CCTV-13《朝闻天下》栏目组的关注,跟踪报道了“2021年度十大类纺织创新产品”的重磅发布,活动由表彰推广、经验分享、时尚发布、供需对接、参观交流等多个部分组成,在展示和推广中国纺织行业的最新创新成果的同时,还为纺织行业上下游搭建了交流与对接的高效平台。
传化化学集团总裁室副总裁、纺化中国区营销中心总经理王浩然以“聚力功能产品创新,助推品牌未来发展”为主题进行了分享。聚焦无氟防水、特种功能整理、绿色低碳工艺的作用机理、加工痛点,为广大纺织服装企业提供了切实有效的系列解决方案。

传化化学集团总裁室副总裁、纺化中国区营销中心总经理 王浩然
传化集团的优势在于?
传化集团创立于1986年,以“成就客户 幸福员工 引领产业”为使命,布局传化化学、新安化工、传化物流、传化科技城四大产业,打造智能制造、物流科技、都市产业新城三大样板,服务和引领“中国智造”进程。
传化化学是一家技术驱动的企业,从基于客户的需求与实际痛点出发,研发出领先的化学解决方案,并将此过程中沉淀出核心共性技术模块拓展到其他丰富的行业应用场景。传化化学在细分市场拥有全球领导地位,纺织化学品的产能全国最大、全球第二市场占有率全国第一;化纤油剂的产销量全球第一,是该领域的行业标准起草单位。

纺织化学品是传化化学最核心的业务板块。经过30多年行业积淀,由单一走向多系列,已形成覆盖印染加工全过程的环保安全产品线,拥有2000个产品品种,有能力为客户提供一站式系统解决方案。
企业注重产品研发,拥有国际一流的研发硬件配置,实验室面积大于2万m2,配备精密分析仪器逾亿元,年技术投入1.5亿元以上。企业顺应数据化建设和智能制造的行业趋势,于2019年产42万吨高端纺织化学品的大江东生产基地正式启用,率先在精细化工领域建立从智能技术、智能产品、智能服务到智能制造的智能新生态。

传化大江东生产基地三车间
功能纺织品的加工痛点和解决方案
传化智联与国家纺织产品开发中心联合组织“纺织面料功能及风格需求预测与纺织化学品助剂开发创新”的调研结果显示,抗菌、吸湿速干、防紫外线等特种功能,防水性能等成为热点问题。在绿色低碳、健康安全、功能舒适的理念指引下,传化在无氟防水、特种功能等功能纺织品方面持续开展技术研究和产品创新开发。
1. 无氟防水的解决方案
PFOA、PFOS已造成全球污染,氟污染问题趋于严重,PFOA是最难降解的有机物,已造成全球污染,甚至在北极地区都有发现;2017年10月27日,世界卫生组织国际癌症研究机构公布的致癌物清单中,将全氟辛酸(PFOA)列为2B类致癌物。目前各国政策法令对含氟化合物的限制已达33种。
(1)无氟防水的作用机理
织物防水的本质是增大液滴与织物表面的接触角,一般通过防水整理实现;织物防水整理是将具有防水作用的功能聚合物,通过水相输送到织物上,并使之在织物表面形成规整、有序的定向排列,发挥防水作用的过程。
含氟防水剂依赖于氟酯单体的强结晶性能,其很容易在织物表面完成规整的定向排列。但是结晶性能较弱的无氟防水剂,想要达到一样的防水效果就会困难得多,因此一般的无氟防水剂都会设计特有的“固定组分”,帮助防水组分完成在织物上的定向排列,各无氟防水剂的性能差异,很大程度上就是固定组分的差异。此外,传化通过采用比较完善的表征方法,比如用接触角更精准地表征最终的防水效果,通过扫描电子显微镜和能谱联用以及临界液体体积法,更为精准地对防水剂在织物表面的分布进行表征。

(2)无氟防水加工痛点和解决方案
a. 如何减少白痕的产生?
无氟防水加工过程中,由于防水剂中石蜡组分、防水剂在纤维表面聚集等原因容易导致白痕出现,无氟防水剂TF-5016A通过减少石蜡组分、降低防水剂粒径的办法可减少白痕的产生。针对较高要求的白痕改善问题,也可选用含硅类无氟防水剂TF-5910。
b. 如何提升防水效果?
无氟防水剂的结晶性差,表面张力偏大,可能出现面料表面不清爽、粘水珠等现象,可采用无氟防水剂TF-5016强防水产品,通过降低无氟防水剂的表面张力、提升结晶性的方式,提高面料的防水效果。
在无氟防水加工过程中,还会存在剥离强度差、耐水压差、纰裂、色变大、洗后晾干性差等痛点,传化也推出了相应的解决方案。

2. 特种功能整理
随着人们对生活品质要求的日益提高,对功能产品的诉求也增多。目前运动休闲健康类服装主要的功能性需求集中在:吸湿速干、抗菌防臭、凉感舒适、防紫外线、抗静电、防蚊虫等方面。
(1)具有优异耐久性能的吸湿速干整理
随着人们休闲活动的增多,运动装服装的需求量也迅猛增长,化纤总占比为86%,而尼龙的吸湿速干性及耐洗性依旧是行业痛点。传化推出的尼龙耐久吸湿速干整理剂TF-620N能够赋予尼龙优异的耐久亲水性、吸湿速干性能、抗静电性,并且不影响织物手感和色牢度。

(2)多维度的凉感整理解决方案
近几年,凉感整理成为市场消费的热点,被称为“穿在身上的空调”。传化可提供三种凉感整理解决方案:PCM相变材料、木糖醇和冰感硅油。
PCM相变材料的凉感机理是将相变材料通过微胶囊包裹,升温时微胶囊从周围环境吸热,使皮肤环境降温,让消费者感觉凉爽。木糖醇吸收体内汗气而产生吸热反应,使温度直接降低,让身体感觉凉爽。冰感硅油可以赋予织物平滑、细腻、冰凉的效果。

(3)“3E”抗菌整理解决方案
随着新冠疫情的爆发,无论是服装还是家纺产品,对于抗菌纺织品的需求均在不断增加。传化通过研究总结了行业关注的诸多问题,例如:菌种繁多,如何选择?抗菌标准如何满足?抗菌要求耐洗50次,能不能做到?抗菌和抗病毒整理的差异?有哪些经济性的抗菌整理?等等……
a. 银离子抗菌整理技术
例如银离子抗菌剂TF-6182,具有极强的抗菌能力,耐水洗50次以上;通过Ag+有效抑制细菌繁殖及异味的产生。
b. 阳离子抗菌整理技术
例如抗菌剂TF-618A,属于阳离子型季铵盐类高分子化合物抗菌剂,可赋予各类纺织品优异的抗菌效果,耐水洗50次以上。
c. 抗菌抗病毒整理技术
例如抗菌抗病毒整理剂TF-6188,适用于各类织物的抗菌、抗病毒整理,可应用于服装、家纺等功能性纺织品及非织造布等。
此外,传化还推出了其他特种功能整理的解决方案,例如防紫外整理、阻燃整理、防蚊虫整理、防干污整理、三防整理等户外防护功能产品;抗静电整理、硬挺整理、免烫整理、易舒展整理、抗微生物整理、易去污整理等家居生活类产品;芳香整理、护肤整理、暖感整理等护肤保健类产品。
3. 节能绿色低碳解决方案
为降低能源消耗,企业越来越注重自身加工工艺的优化升级,主动采用节能减排、高效短流程等绿色低碳工艺方案来替代传统高耗能、高污染工艺,以实现企业的绿色化转型发展。
(1)低温前处理工艺
传化在10年前已开发推广棉低温前处理工艺方案,通过关键技术控制双氧水的有效转化分解,成功实现在60~80℃练漂温度下,达到传统高温练漂的效果,为企业节能降耗。
(2)优佳净染色工艺
在涤纶织物染色方面,通过在染色工序中组合使用染中保TF-256和染中素TF-257,可在碱减量加工后省去复练工序,提高加工效率,并有效减少缸差问题,提高染色一次成功率。
(3)其他绿色低碳工艺
此外,传化还推出了棉长车前处理解决方案、羽绒中低温清洗方案、薄型涤纶连续退浆方案、涤纶难染染料染色成功率提升方案、尼龙节能固色方案、涤棉针织免漂染色方案、涤纶短流程染色工艺方案、涤纶高牢度酸性还原清洗工艺、棉节水皂洗工艺、T/R干湿摩擦色牢度提升方案、涤纶无水轧染技术、涤纶免水洗印花方案、凹版无醇水墨印花技术方案、涂料仿活性印花工艺等绿色低碳工艺,助力行业实现“碳中和”的美好愿景。
※ 有关作品版权事宜请联系:010-84463638转8850 电子邮箱:info#texleader.com.cn
bet伟德娱乐手机版官方微信


© 2025 伟德的真网址 版权所有
京ICP备10009259号-3
 京公网安备 11010502045125号
京公网安备 11010502045125号